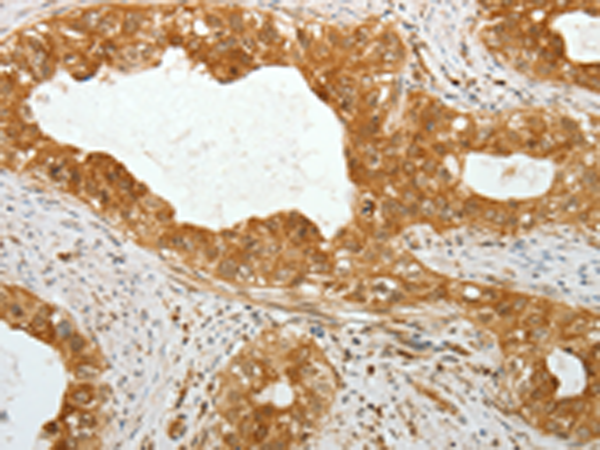

-
分类: 科研抗体货号: P00746别名:应用: WB,IHC反应种属: Human, Mouse, Rat
-
分类: 科研抗体货号: P00745别名:应用: WB,IHC反应种属: Human, Mouse, Rat
-
分类: 科研抗体货号: P00740别名: CED; LAP; DPD1; TGFB; IBDIMDE; TGFbeta应用: WB,IHC反应种属: Human, Mouse, Rat
-
分类: 科研抗体货号: P00789别名: TDT应用: WB,IHC反应种属: Human
-
分类: 科研抗体货号: P00825别名: ACH2; CTE-1; LACH2应用: IHC反应种属: Human
-
分类: 科研抗体货号: P00781别名: WIP1; PP2C-DELTA应用: IHC反应种属: Human, Mouse
-
分类: 科研抗体货号: P00816别名: AIP1; ABI-2; ABI2B; AIP-1; AblBP3; argBP1; SSH3BP2; argBPIA; argBPIB应用: WB反应种属: Human, Mouse
-
分类: 科研抗体货号: P00779别名: RCA1; VHL1; pVHL; HRCA1应用: IHC反应种属: Human
-
分类: 科研抗体货号: P00815别名: CGI58; IECN2; NCIE2应用: IHC反应种属: Human, Mouse, Rat
-
分类: 科研抗体货号: P00770别名: SPGF6; NYD-SP12应用: WB,IHC反应种属: Human, Mouse

鄂公网安备42018502007531号
鄂公网安备42018502007531号

